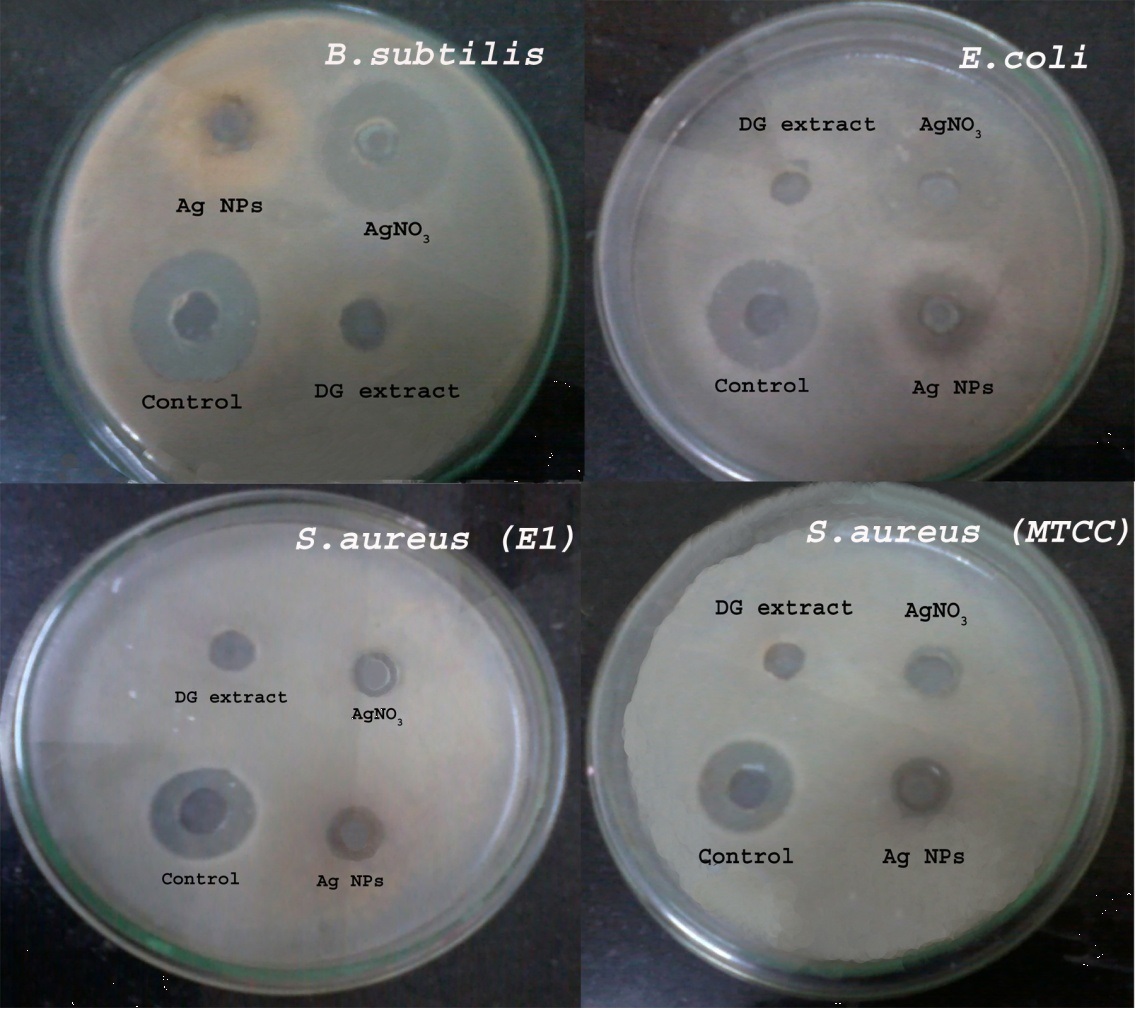

Int J Pharm Pharm Sci, Vol 7, Suppl 1, 182-186Original Article
CHARACTERIZATION AND BIOLOGICAL EVALUATION OF SILVER NANOPARTICLES SYNTHESIZED BY AQUEOUS ROOT EXTRACT OF DESMODIUM GANGETICUM FOR ITS ANTIOXIDANT, ANTIMICROBIAL AND CYTOTOXICITY
VIVEK VISHNU A@, SUBHASH N@, SHAKILABANU A@, GINO A KURIAN@*
@School of Chemical and Biotechnology, SASTRA University, Thanjavur, Tamil Nadu
Email: ginokurian@hotmail.com
Received: 07 Nov 2014 Revised and Accepted: 05 Dec 2014
ABSTRACT
Obective: To evaluate the biological significance of silver nanoparticles synthesized by aqueous root of Desmodium gangeticum and to understand its antioxidant, antimicrobial and cytotoxic activity.
Methods: In the present study silver nanoparticles (AgNPs) were synthesized with precursor silver nitrate using aqueous root extract of Desmodium gangeticum (DG). Chemical synthesis of AgNPs was done by following the procedure by Guzman et. al (2009) with little modification. The AgNPs were further characterized by different techniques like UV-visible Spectrometer, X-ray Diffraction (XRD), Fourier Transform Infra-Red spectroscopy (FTIR), Scanning electron microscopy (SEM) and Thermo Gravimetric Analysis (TGA).
Results: The presence of silver nanoparticles with an average size between 30-40 nm and exhibiting face centred cubic structure was confirmed. SEM reveals the morphology of the nanoparticles as spherical and the IR spectra confirms the presence of phyto-constituents in AgNPs that not only acts as reducing agent, but also stabilize the particles. Biological evaluation of the nanoparticles showed significant antimicrobial and antioxidant activity. AgNPs possess relatively low cytotoxicity to LLC-PK1 cells compared to DG extract and the precursor silver nitrate.
Conclusion: Biological evaluation of the nanoparticles showed significant antimicrobial and antioxidant activity. AgNPs possess relatively low cytotoxicity to LLC-PK1 cells compared to DG extract and the precursor silver nitrate. Compared to physical and chemical method of nanoparticle synthesis, biological procedure is ecofriendly and cost effective.
Keywords: AgNPs, Desmodium gangeticum, Antioxidant, Antimicrobial, LLC-PK1 cell line.
INTRODUCTION
Nanotechnology is a rapidly growing field of science with several technological innovations being reported in recent times. The properties of nano sized particles have been widely exploited in different applications such as optical [1], magnetic [2], electronic [3], thermal [4] and catalytic activities [5]. Among the nanoparticles, silver has been known for its unique physical, chemical and biological properties which makes them the most resourceful.
Silver nanoparticles are extensively used in many applications like formulation of dental resin composites, disinfectants, bactericidal coatings in water filters [6]. It was also used as an antimicrobial agent in air sanitizer sprays, respirators, socks, wet wipes, pillows, detergents, soaps, washing machines, shampoos, toothpastes and many other consumer products. In medicinal field it is used as bone cement, inks [7], microelectronics [8], medical imaging [9] and in wound dressing applications [10].
Synthesis of nanoparticles is mediated through a number of approaches such as chemical [11], physical [12] and biological [13] [14]. Indeed, most of the chemical methods used for the synthesis of silver nanoparticles are too expensive and also involves the use of toxic, hazardous chemicals which are responsible for various biological risks [15]. This enhances the growing need to develop environment friendly processes like green synthesis and other biological approaches.
The synthesis of nanoparticles using various plants can be advantageous over other biological synthetic approaches like fungi and bacteria. The latter in particular may involve complex procedures for maintaining the cultures and can be scaled-up for large scale production under non aseptic environments, as well. Lonicera Japonica [16], Dioscorea batatas [17], Magnolia kobus [18], Cinamomum camphora [19] and Geranium species [20] are some of the plants used to synthesize nanoparticles. Since solvent toxicity is one of the major drawbacks in the preparation of silver nanoparticles, the need for a newer agent still persists.
Desmodium gangeticum (Fabaceae family) is widely used in Indian System of Medicine for different diseases and was proven to have highest reducing potential [21]. It was widely used against inflammation [22], fever, ischemia reperfusion injury [23], myocardial infarction [24] analgesic activities and other neurological imbalances [25]. Chemical studies on the Desmodium gangeticum revealed the presence of alkaloids, pterocarpnoids, flavonoids and iso-flavonoids glycosides that may play an important role in the reduction of the raw metals into nanomaterials [26].
This study has been undertaken to prepare silver nanoparticles by using an aqueous extract of Desmodium gangeticum roots to evaluate its antioxidant and antibacterial activity, assess its suitability as a therapeutic agent. Furthermore, the cytotoxic nature of AgNPs was analyzed in LLC-PK1 epithelial cell line.
MATERIALS AND METHODS
In the present study, Desmodium gangeticum (Linn) DC (DG) roots were collected from ST. Berchmanns’ college botanical garden at Changanacherry in Kerala (India), which was authenticated by Head of the Department (Botany) of Saint Berchman’s Collage. Mahatma Gandhi University, Kerala. The voucher specimen A/C no. 3908 was retained in our laboratory for future reference. Silver nitrate (AgNO3) was procured from Sigma–Aldrich Chemical Pvt. Limited and all chemicals used were of analytical grade.
Preparation of plant extract
One kilogram (1 kg) of fresh secondary roots of DG was sliced and air-dried at room temperature. The air-dried roots were milled into fine powder in a commercial blender. The powder was Soxlet extracted with 2.5 liters of distilled water at 37oC for 24 hours. The combined aqueous extracts were filtered and concentrated to dryness under reduced pressure at 30±1oC. The resulting aqueous extract was freeze-dried, finally giving 18.66 g [i.e., 1.866% yield] of a light-brown, powdery crude aqueous root extract of DG. Aliquot portions of the crude root aqueous extract residue was weighed and dissolved in distilled water (25 mg/ml) for use on each day of our experiment. Preliminary qualitative thin layer chromatography analysis of the aqueous extract showed the presence of alkaloids (Dragendorffs reagent), flavones (Shinoda test and Uranium acetate test), Phenols (4 amino anti pyrine test) and steroids (para-toluene sulfonic acid test).
Green synthesis of silver nanoparticles
The synthesis of silver nanoparticles was carried out by a modified method. Briefly, 5 mm aqueous solutions of silver nitrate were prepared and used for the synthesis of silver nanoparticles. 25 ml of DG aqueous extract was added into 75 ml of of silver nitrate solution for reduction of Ag+ions and heated for 30 min at 80 ˚C: the change of color takes place within a few minutes from yellowish to reddish brown color. The mixture was centrifuged at 2000 rpm for 5 min and the supernatant was removed. The pellet was washed twice with distilled water and air dried. The obtained black colored particles were stored and characterized further.
Characterization of silver nanoparticles
The absorption spectrum of the silver nanoparticles (AgNP) was recorded using UV-Visible spectrophotometer in the wavelength range of 300-800 nm. Crystalline structure of biosynthesized silver nanoparticles was examined using X-ray diffraction analysis (Ultima IV instrument, Rigako). It was recorded in a wide range of Bragg angles θ using optimum operating conditions (40 kV and 30 mA) at a scanning rate of 2 °min−1, with Cu Kα target as an radiation source (λ-1.5405 Å). FTIR spectral analysis was used to identify the functional groups present in silver nanoparticles and DG extract. FTIR was recorded on a Perkin Elmer FT-IR system (Spectrum GX mode) in the frequency range of 400-4000 cm-1 at 4 cm-1 resolution. Size and morphology of silver nanoparticles were studied using scanning electron microscopy technique. The Image was recorded on JEOL-JEM 6390 instrument (Japan Make) at 40, 000 x magnifications with an operating voltage of 20 KV. Thermal stability of biosynthesized silver nanoparticles and aqueous Desmodium gangeticum root extract by thermo gravimetric analytic technique. The percentage weight loss with respect to temperature was recorded in the temperature range from 0 oC to 1000 oC at a heating rate of 10 oC/min, using SDT-Q600 model, TA instrument (USA).
DPPH, Total phenol assay and reducing power assay
The free radical scavenging effect of DG extract and silver nanoparticles on DPPH free radical was carried out according to Solver-Rivas et al. (2000) with slight modification [27]. Total phenol was measured by Folin-Ciocalteau reagent in alkaline medium [28]. Reducing the potential of biosynthesized silver nanoparticles and DG extract was determined by Oyaizu method [29].
Antimicrobial activity
The antimicrobial activity of the silver nanoparticles was determined using agar well diffusion method [30]. 25 mL of molten and cooled Mueller Hinton agar was poured in sterilized petri dishes. The plates were left overnight at room temperature to check for any contamination. All the bacterial test organisms were grown in Mueller Hinton broth for 24 hours. Agar wells (8 mm dia) were prepared with the help of a sterilized stainless steel cork borer.
The nutrient broth culture (100 µl) of each bacterial organism was used to prepare bacterial lawns in petri dishes. The wells were then loaded with 100 μl sample (silver nanoparticle, precursor (AgNO3) and aqueous DG extract). The inoculated plates were incubated overnight at 37 °C and checked for antimicrobial activity. Ciprofloxacin was used as a positive control.
Toxicology
Cytotoxicity of silver nanoparticles in LLC-PK1 was determined using lactate dehydrogenase (LDH) assay [31]. In principle, the released amount of lactate dehydrogenase enzyme from damaged cells into the medium was determined. Cells were cultured in 96-well plate for 24 hours. After it reached 50% confluency, cells were treated with silver nanoparticles, precursor (AgNO3) and aqueous DG extract. After 24 hours of treatment, 50 µl of culture medium was collected and incubated with the reaction mixture consisting of NAD+(50 µl), lactate (50 µl) and 0.2 M (pH 7.4) Phosphate buffer (50 µl). The absorbance was measured at 340 nm.
Statistical analysis
All statistical analyses were performed using Graph Pad Prism 5.0 software. Data signify the means±S. D of three samples and were representative of three independent experiments.
RESULTS AND DISCUSSION
Characterization of silver nanoparticles
Characterization of silver nano particles were done by using UV-vis spectrophotometer, FTIR, X-ray diffraction, Thermo Gravimetric Analysis and Scanning electron microscope.

Fig. 1: Characterization of silver nanoparticles by UV-Visible Spectroscopy, FTIR Spectroscopy, XRD and TGA
UV-Visible spectral analysis
Interaction of silver nanoparticles with light depends on its environment, size and physical dimensions. UV–Visible spectrophotometer is widely used technique for characterization of AgNPs [32]. Upon the incidence of the light ray on the metal (silver) nanoparticles, Surface Plasmon vibration originates due to oscillation of an electron charge which can be measured at 456 nm [33]. From fig. (1A) the presence of AgNPs was confirmed and also physically verified by its color change from brown to blackish red within 30 min. Early report suggests that single SPR band in the absorption spectra for spherical metal nanoparticles and two or more SPR bands for anisotropic particles [34] therefore AgNPs prepared by DG extract showing single, sharp SPR band confers spherical shape of AgNPs. Furthermore, solution of biosynthesized silver nanoparticles was very stable even for more than one month.
FTIR analysis
The interaction between different functional groups and changes in chemical composition of the mixture undergone during AgNPs production was investigated by FTIR spectroscopy. Fig.1 (B and C) shows IR spectra of silver nanoparticles and aqueous DG root extract. The IR spectrum (Fig.1B) shows absorption bands at wave number (cm-1) 3401, 2925, 2852, 1615, 1384, 1334, 1319, 1048, 596 and 509 for silver nanoparticles while Desmodium gangeticum root extract (Fig.1C) showed bands at wave number (cm-1) 3746, 3404, 2928, 2114, 1622, 140, 1079, 1027 and 671. Both DG and AgNPs showed common strong absorption peaks at 3404 and 3401 cm-1 which refers to O-H stretching (phenols or hydroxyl groups) [35]; 2928 and 2925 cm-1 refers to O-H stretching of carboxylic acid; 1622 and 1615 cm-1 refers C=O stretching; 1400 and 1384 cm-1 refers to C=N stretching in aromatic amines; 1079 and 1048 cm-1 refers C=N stretching. Thus, confirming the association of DG phyto-compounds such as phenols, proteins and sterols with silver and their ability to act as an effective reducing as well as capping agent in silver nanoparticles synthesis.
XRD (X-ray Diffractometry)
X-ray Diffraction analysis was used to identify the phases and crystalline structure of AgNPs. The XRD pattern of Ag nanoparticles is shown in (fig. 1D). Sharp diffraction peaks emerges at 2θ = 32.80o, 44.04o, 64.34o and 77.28o corresponds to (111), (200), (220) and (311) Bragg’s reflections respectively which were assigned to be face centered cubical structure for silver phase. However, the peaks at 2θ = 27.96o, 38.28o and 46.18o (denoted by *) might be related to crystalline and organic phases indicating hexagonal phased crystal [36]. Average particle size was calculated as 0.24 nm using Scherer’s equation:
 -----Eqn-1
-----Eqn-1
where D is the crystallite size of AgNPs, λ is the wavelength of the X-ray source (0.1541 nm) used in XRD, β is the full width at half maximum of the diffraction peak, K is the Scherrer constant with a value from 0.9 to1 and θ is the Bragg angle.
TGA (Thermo gravimetric analysis)
The physicochemical interaction between silver nanoparticles and DG was further characterized by thermo-gravimetric analysis (fig. 1E and 1F). The existence of physiochemical moisture either in the form of physical adsorption or in the chemically bound hydroxyl group was analysed by TGA. DG aqueous extract was observed to have a linear weight loss until 700 οC. However, bound onto the silver nanoparticle surface, DG exhibits a delayed decomposition. In fact at 700 οC, DG extract showed a 65% weight loss while AgNPs showed only 31% weight loss. Higher stability of AgNPs in TGA analysis indicates the presence of assosciated phyto-constituents with high melting point. From the GC-MS results shown in our previous study, the probable compound assosciated with AgNPs might be stigmasterol, genistein, caffeic acid or phenyethylamine [37]. Relatively high TGA indicates that it might be useful for many applications, such as low sintering temperature of Ag paste, ink for printable electronics and as a potent drug delivery agent in biomedicine.
Morphological analysis of DG silver nanoparticles by SEM
The external features and morphology of the AgNPs was observed with scanning electron microscopy (JEOL F-6400). SEM result suggests that the AgNPs showed less aggregation and particles were more spherical in shape with size ranging from 30 to 40 nm in diameter. The average size was found to be 37 nm, confirming the development of nanostructures (fig. 2).

Fig. 2: Scanning electron microscopic image of biosynthesized silver nanoparticles
Biological effect of the silver nano particles
It is known that silver nanoparticles can render protection against bacterial infection. Silver as such is a safe metal; however, the antibacterial effect is due to its ionic form. Hence it became relevant to assess the anti microbial property of DG synthesized silver nano particles.
Antimicrobial effect
The effects of AgNPs against Gram negative (E. coli-MTCC 574) and Gram positive bacteria (S. aureus-MTCC3160, S. aureus-E1 strain, B. subtilis-MTCC 2413) were investigated using the well diffusion method. The inhibition zones diameter mediated by AgNPs, AgNO3 and DG extract (fig. 3) was analyzed by Image J software and the results were shown in table 1. The antibacterial activity of Ag nanoparticles was significantly high with respect to DG extract but not with AgNO3. Irrespective of the nature of the strains (Gram positive or Gram negative), Ag nanoparticles showed good antibacterial property. Compared to positive control (ciprofloxacin), bactericidal activity of AgNPs was low indicating the stability of AgNPs, as interaction of silver ions and bacteria is a pre-requisite for antimicrobial action. It was postulated that interaction of silver ions with thiol groups in enzymes and proteins in bacteria mediates its destruction( [38]). Enhanced bactericidal activity of AgNPs in E. coli and B. subtilis indicates that it may inhibit both Gram negative and Gram positive bacterial growth effectively.
Fig. 3: Anti-bacterial activity of silver nanoparticles
Table 1: Zone of inhibition of silver nanoparticles, DG extract, silver nitrate and ciprofloxacin (control) against E. coli, S. aureus, S. aureus and B. subtilis
| Inhibition zones(mm) |
| Strains |
| E. coli(MTCC 574) |
| S. aureus(MTCC 3160) |
| S. aureus(E 1) |
| B. subtilis(MTCC 2413) |
DPPH radical quenching ability, Reducing power and total phenol

Fig. 4: DPPH scavenging activity of silver nanoparticles
The DPPH radical quenching ability of AgNPs was analyzed to predict the antioxidant potential of nanoparticles. Our results showed a dose dependent scavenging action of AgNPs and are shown in Fig.4. The DPPH free radical scavenging assay showed potent inhibitory capacity of both DG extract and AgNPs when compared with ascorbic acid (fig. 4). The maximum inhibition was observed to be around 62% at (1000µg/ml) concentration and minimum inhibition was around 58% at (32.5µg/ml) concentration. Different studies have indicated that reducing power of a compound is related to its antioxidant potential. Fig. 5 A shows the reducing potential of DG extract and AgNPs which was found to be more or less same. Significant reducing power of AgNP observed in our study support potential free radical scavenging activity of the compound that may be non-phenolic in nature as the phenolic compounds in AgNPs is much less compared to DG extract. In general, phenolic compounds are attributed to have high reduction potential, and the antioxidant property depends on the structure number and positions of the hydroxyl groups and the nature of substitutions on the aromatic rings. Our results (fig. 5B) suggest relatively low phenol content in AgNPs. The total phenol content was higher in DG extract (1.9 mg/g ascorbic acid) compared to silver nanoparticles (0.03 mg/g ascorbic acid).
Toxicology
To investigate the cytotoxic nature of silver nanoparticles, LDH leakage from the cell was measured and that serves as a sensitive and effective marker for cellular toxicity. After 24 hours of treatment of LLC-PK1 cell lines with AgNPs, AgNO3 and DG, LDH activity was measured and found to be less in cells treated with silver nanoparticles compared to those treated with its precursor silver nitrate and DG extract alone. In Fig.6, silver nitrate showed the highest toxicity while silver nanoparticles showed the least suggesting that its bio-compatible.

Fig. 5: Reducing power and total phenol content of Silver nanoparticles

Fig. 6: LDH activity of silver nanoparticles in culture medium of LLC-PK1 cells
CONCLUSION
The present study is truly a cost-effective green approach, capable of producing silver nanoparticles from silver nitrate using Desmodium gangeticum root extract. The sizes of the silver nanoparticle prepared were in the range of 35-40 nm with spherical geometry and was face centered cubic crystalline in nature. Apparently significant antimicrobial activity was shown by AgNP against various gram positive and gram negative bacteria, and these nanoparticles possessed good antioxidative property, as well. Indeed, the silver nanoparticles prepared by DG extract were non-toxic and can be used as a potent therapeutic agent in the biomedicine field.
ACKNOWLEDGMENT
The authors greatly thank SASTRA University for providing laboratory facilities and Dr. P. Brindha, Dean of CARISM (Centre for Advanced Research in India Systems of Medicine) department, SASTRA University for her support and generous assistance.
CONFLICT OF INTERESTS
Declared None
REFERENCES
- Murphy CJ, Sau TK, Gole AM, Orendorff CJ, Gao J, Gou L, et al. Anisotropic metal nanoparticles: Synthesis, assembly, and optical applications. J Phys Chem 2005;28;109(29):13857-70.
- Shipway AN, Katz E, Willner I. Nanoparticle arrays on surfaces for electronic, optical, and sensor applications. Chem Phys Chem 2000;1(1):18-52.
- Pankhurst QA, Connolly J, Jones S, Dobson JJ. Applications of magnetic nanoparticles in biomedicine. J Phys D: Appl Phys 2003;36:R167.
- Jin H, Kang KA. Application of novel metal nanoparticles as Optical/Thermal agents in optical mammography and hyperthermic treatment for breast cancer. Adv Exp Med Biol 2005;599:45-52.
- Moshfegh AJ. Nanoparticle catalysts. J Phys D: Appl Phys 2009;42:233001.
- NTP Phong, NVK Thanh, PH Phuong. Fabrication of antibacterial water filter by coating silver nanoparticles on flexible polyurethane foams. J Phys: Conf Ser 2005;187:012079.
- Zhang Z, Zhang X, Xin Z, Deng M, Wen Y, Song Y. Synthesis of monodisperse silver nanoparticles for ink-jet printed flexible electronics. Nanotechnol 2011;22(42):425601.
- Thirumalai Arasu V, Prabhu D, Soniya MJ. Stable silver nanoparticle synthesizing methods and its applications. J Biosci Res 2010;1:259-70.
- Prabhu S, Poulose EK. Silver nanoparticles: mechanism of antimicrobial action, synthesis, medical applications, and toxicity effects. Nano Lett 2012;8:1–10.
- Wilkinson L, White R, Chipman J. Silver and Nanoparticles of silver in wound dressings: A review of efficacy and safety. J Wound Care 2011;20:543-9.
- Guzmán MG, Dille J, Godet S. Synthesis of silver nanoparticles by chemical reduction method and their antibacterial activity. Int J Chem Biomol Eng 2009;2:104-11.
- Rodriguez-Sanchez L, Blanco MC, Lopez-Quintela MA. Electrochemical synthesis of silver nanoparticles. J Phys Chem B 2000;104:9683–8.
- Mubayi A, Chatterji S, Rai PM, Watal G. Evidence based green synthesis of nanoparticles. Adv Mater Lett 2012;3(6):519-25.
- Salam HA, Rajiv P, Kamaraj M, Jagadeeswaran P, Gunalan S, Sivaraj R. Plants: green route for nanoparticle synthesis. Int Res J Biol Sci 2012;1:85–90.
- C Marambio-Jones, EMV Hoek. A review of the antibacterial effects of silver nanomaterials and potential implications for human health and the environment. J Nanopart Res 2010;12:1531-51.
- Nagajyothi PC, Lee SE, An M, Lee KD. Green synthesis of silver and gold nanoparticles using Lonicera japonica flower extract. Bull Korean Chem Soc. 2012;33(8):2609–12.
- Nagajyothi P, Lee KJ. Synthesis of plant-mediated silver nanoparticles using dioscorea batatas rhizome extract and evaluation of their antimicrobial activities. J Nanomater 2011;49:573429.
- Lee HJ, Song JY, Kim BS. Biological synthesis of copper nanoparticles using Magnolia kobus leaf extract and their antibacterial activity. J Chem Tech Biotechnol 2013;88:1971-7.
- J Huang, Q Li, D Sun, Y Lu, Y Su, et al. Biosynthesis of silver and gold nanoparticles by novel sundried cinnamomum camphora Leaf. Nanotechnol 2007;18:105104-15.
- Shankar SS, Rai A, Ankamwar B, Singh A, Ahmad A, Sastry M. Biological synthesis of triangular gold nanoprisms. Nat Mater 2004;3:482–8.
- Kurian GA, Suryanarayanan S, Raman A, Padikkala J. Antioxidant effects of ethyl acetate extract of Desmodium gangeticum root on myocardial ischemia reperfusion injury in rat hearts. Chin Med 2010;5:3.
- Rathi A, Rao CV, Ravishankar B, De S, Mehrotra S. Anti-inflammatory and anti-nociceptive activity of the water decoction Desmodium gangeticum. J Ethnopharmacol 2004;9:259-63.
- Kurian GA, Rajamani T, Ramanarayanan P, Padikkala J. A comparative study on in-vitro and in-vivo antioxidant activities of aqueous extract of Desmodium gangeticum DC (Leguminosae) root. Int J Green Pharm 2009;3(4):324-31.
- Kurian GA, Philip S, Varghese T. Effect of aqueous extract of the Desmodium gangeticum DC root in the severity of myocardial infarction. J Ethnopharmacol 2005;97(3):457-61.
- Lai SC, Peng WH, Huang SC, Ho YL, Huang TH, Lai ZR, et al. Analgesic and anti-inflammatory activities of methanol extract from Desmodium triflorum DC in mice. Am J Chin Med 2009;37:573-88.
- Mishra PK, Singh N, Ahmad G, Dube A, Maurya R. Glycolipids and other constituents from Desmodium gangeticum with antileishmanial and immunomodulatory activities. Bioorg Med Chem Lett 2005;15:4543-6.
- Jayachitra A, Krithiga N. Study on antioxidant property in selected medicinal plant extracts. Int J Med Arom Plants 2012;2:495-500.
- Patel A, Patel NM. Determination of polyphenols and freeradical scavenging activity of Tephrosia purpurea linn leaves (Leguminosae). J Phcog Res 2010;2:152–8.
- ICFR Ferreira, P Baptista, M Vilas-Boas, L Barros. Free-radical scavenging capacity and reducing power of wild edible mushrooms from northeast Portugal: individual cap and stipe activity. Food Chem 2007;100(4):1511–6.
- Valgas C, Souza SM, Smânia EFA, Smânia A Jr. Screening methods to determine antibacterial activity of natural products. Braz J Microbiol 2007;38:369–80.
- Decker T, Lohmann-Matthes ML. A quick and simple method for the quantitation of lactate dehydrogenase release in measurements of cellular cytotoxicity and tumor necrosis factor (TNF) activity. J Immunol Methods 1988;115:61–9.
- Chudasama B, Vala AK, Andhariya N, Upadhyay RV, Mehta RV. "Enhanced antibacterial activity of bifunctional Fe3O4–Ag core–shell nanostructures". Nano Res. 2009;2:955-65.
- T Premkumar, Y Lee, KE Geckeler. Macrocycles as a tool: a facile and one-pot synthesis of silver nanoparticles using cucurbituril designed for cancer therapeutics. Chem A Eur J 2010;16:11563-6.
- Novak JP, Brousseau LC, Vance FW, Johnson RC, Lemon BI, Hupp JT, et al. Nonlinear optical properties of molecularly bridged gold nanoparticle arrays. J Am Chem Soc 2000;122:12029-30.
- Singhal G, Bhavesh R, Kasariya K, Sharma AR, Singh RP. Biosynthesis of silver nanoparticles using Ocimumsanctum (Tulsi) leaf extract and screening its antimicrobialactivity. J Nanopar Res 2011;13:2981–8.
- Awwad AM, Salem NM, Abdeen AO. Green synthesis of silver nanoparticles using carob leaf extract and its antibacterial activity. Int J Ind Chem 2013;4:1-6.
- Shabi MM, Paddikkala J. Cardiotonic and anti ischemic reperfusion injury effect of Desmodium gangeticum root methanol extract. Turk J Biochem 2010;35(2):83–90.
- Liau SY, DC Read, WJ Pugh, JR Furr, AD Russell. Interaction of silver nitrate with readily identifiable groups: relationship to the antibacterial action of silver ions. Lett Appl Microbiol 1997;25:279-83.